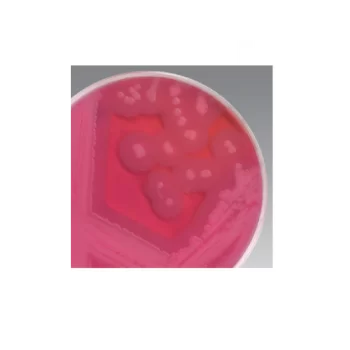
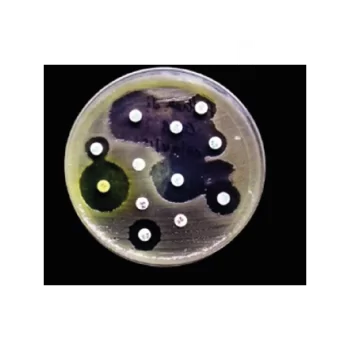

Showing 82–90 of 194 results
Mueller Hinton Broth (Dehydrated) / Caldo Mueller Hinton (deshidratado)
S/ 0.00
[SKU: CM0405B]
Realice pruebas de susceptibilidad antimicrobiana (AST) sin esfuerzo utilizando el caldo Mueller Hinton Thermo Scientific™ Oxoid™ (deshidratado), un medio que se puede utilizar en procedimientos estándar reconocidos internacionalmente.
Muller-Kauffmann Tetrathionate-Novobiocin Broth (MkTTn) / Caldo de tetrationato-novobiocina de Müller-Kauffmann (MkTTn)
S/ 0.00
[SKU: CM1048B]
Aísle selectivamente especies de Salmonella de muestras de alimentos con el caldo de tetrationato-novobiocina Thermo Scientific™ Muller-Kauffmann (MkTTn) para realizar pruebas de alimentos de conformidad con la norma ISO 6579:2002.
MYP Agar (Dehydrated) / Agar PAI (deshidratado)
S/ 0.00
[SKU: CM0929B]
Enumere Bacillus cereus en muestras de alimentos con medio selectivo y diferencial Thermo Scientific™ Oxoid™ MYP Agar (deshidratado). Las características diagnósticas del medio dependen de que Bacillus cereus no utilice manitol y de la capacidad de la mayoría de las cepas para producir fosfolipasa C, lo que da como resultado un halo opaco alrededor de las colonias.
Neomycin Antimicrobial Susceptibility discs (Vet) / Discos de susceptibilidad antimicrobiana a neomicina Oxoid (veterinario)
S/ 0.00
[SKU: CT0033B]
Determine manualmente la susceptibilidad a los antibióticos de los microorganismos mediante métodos de prueba de susceptibilidad a los antimicrobianos (AST) junto con discos de susceptibilidad a los antimicrobianos de neomicina Thermo Scientific™ Oxoid™, fiables y fáciles de usar.
Netilmicin Discs for Oxoid™ Antibiogram / Discos de netilmicina para antibiograma Oxoid™
S/ 0.00
[SKU: CT0225B]
Evalúe la sensibilidad de los microorganismos utilizando métodos AST manuales, con la ayuda de una amplia selección de discos para antibiogramas.
Novobiocin discs for Oxoid™ antibiogram / Discos de novobiocina para antibiograma Oxoid™
S/ 0.00
[SKU: CT0038B]
Evalúe la sensibilidad de los microorganismos utilizando métodos AST manuales, con la ayuda de una amplia selección de discos para antibiogramas.
Nutrient Agar (Dehydrated) / Agar Nutriente (Deshidratado)
S/ 0.00
[SKU: CM0003B]
Cultive y aísle patógenos exigentes y otros microorganismos con el agar nutritivo Thermo Scientific™ Oxoid™ (deshidratado).
Nutrient Broth (Dehydrated) / Caldo Nutritivo (Deshidratado)
S/ 0.00
[SKU: CM0001B]
Cultive patógenos exigentes y otros microorganismos con el nutritivo caldo de nutrientes Thermo Scientific™ Oxoid™ (deshidratado).
Oxacillin discs for Oxoid™ antibiogram / Discos de oxacilina para antibiograma Oxoid™
S/ 0.00
[SKU: CT0040B]
Evalúe la sensibilidad de los microorganismos utilizando métodos AST manuales, con la ayuda de una amplia selección de discos para antibiogramas.